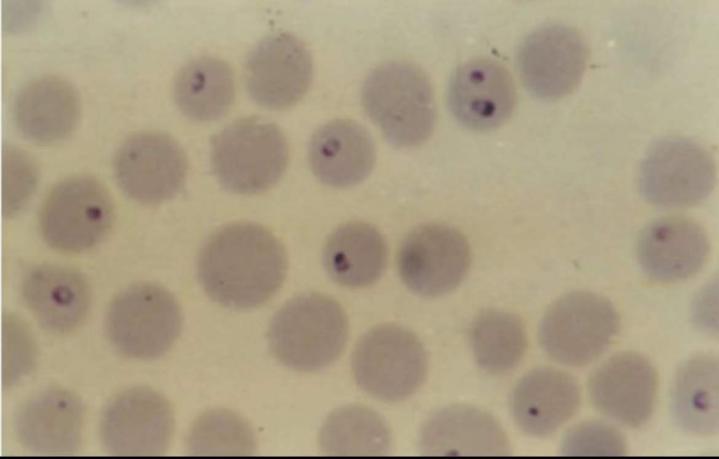
2022x9CtUs2Z991659433253.jpeg

(2021 B卷 综合 19-21)奶牛,高热稽留,可视粘膜苍白,黄染,尿液红色,血涂片染色镜检如图所示病原。传播该病的媒介是
巴贝斯病是由巴贝斯虫(图1)寄生于牛红细胞内引起的疾病,主要病原有双芽巴贝斯虫、牛巴贝斯虫、卵形巴贝斯虫,其形态区别见表1,此病皆通过硬蜱传播,病牛首先表现高热稽留,后期由于红细胞大量破坏,血红蛋白从肾脏排出而出现血红蛋白尿,尿的颜色由淡红色变为棕红色乃至黑红色,同时贫血、黄疸。
血液涂片检出虫体是确诊的主要依据。
常用的特效药为咪唑苯脲、三氮脒、锥黄素(吖啶黄)、硫酸喹啉脲等。
图1 双芽巴贝斯虫 图2 牛巴贝斯虫 图3 卵形巴贝斯虫牛巴贝斯病病原比较如下:双芽巴贝斯虫:长度大于红细胞半径,多形性,典型形状是成双的梨籽形,尖端锐角相连。
牛巴贝斯虫:长度小于红细胞半径,多形性,典型形状是成双的梨籽形,尖端以钝角相连。
卵形巴贝斯虫:长度大于红细胞半径,多形性,典型虫体中央不着色,形成空泡,双梨籽形虫体较短以锐角或钝角相连或不相连。
《兽药管理条例》第四十七条规定的按照假兽药处理的情形是()
猪,采食烂青菜后,站立不稳,呼吸困难,脉搏细弱,全身发绀,其可能的发病机制是(2016 真题上 89)
“槟榔肝”是指慢性肝淤血伴发肝细胞(2014 真题上 59)
一病死仔猪,剖检见颌下淋巴结和腹股沟淋巴结明显肿胀,呈灰白色,质地柔软,肺、肝和肾等表面均见有大小不一的灰白色隆起,切开病灶见灰黄色混浊的凝乳状物流出。确诊该病需进一步检査的项目是(2017 真题上 97)
与炎性渗出有关的因素是(2011 真题上 65)
磺胺类药抑制二氢叶酸合成酶的机制属于(2023 基础)
目前,水产养殖中常发生的所谓“鱼类肝胆综合征”的肝脏切片中,可以看到肝脏肿大,被膜紧张,边缘钝圆,色变黄,切面隆起,有油腻感,质地脆软。该病在病因消除后通常可恢复正常,严重时易引发肝细胞
贫血对机体的影响取决于下列哪些因素
经营普药的企业必须具备的条件是()
许多核苷酸在调节代谢中起着重要作用,其中参与动物磷脂合成的核苷酸是